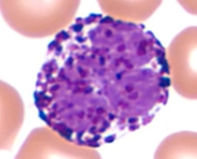
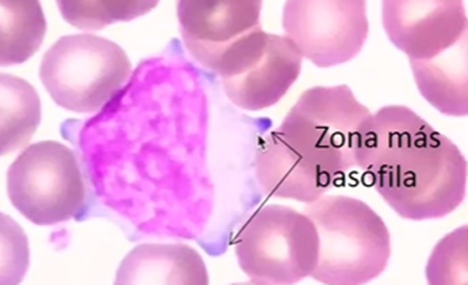
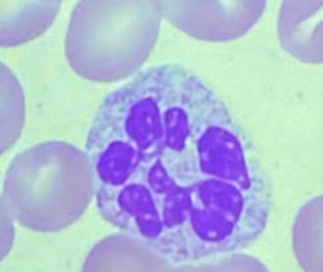

1/23
Looks like no tags are added yet.
Name | Mastery | Learn | Test | Matching | Spaced | Call with Kai |
|---|
No analytics yet
Send a link to your students to track their progress

Mieloblasto Neutrófilo

Promielocito Neutrófilo

Mielocito Neutrófilo

Metamielocito Neutrófilo

Neutrófilo en banda

Neutrófilo segmentado

Promielocito eosinófilo

Mielocito eosinófilo

Metamielocito eosinófilo

Eosinófilo segmentado

Promielocito basófilo
Basófilo maduro

Célula cebada

Monocito

Macrófago

Célula plasmática
Linfocito T efector

Célula NK

Monocito en transformación a macrófago

Linfocito plasmocitoide

Cuerpos apoptóticos
Neutrófilo hipersegmentado

Proplaqueta

Preplaqueta